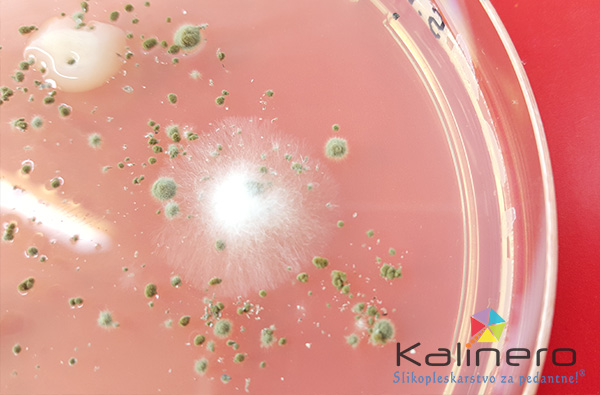
plesen na silikonu

"Imam plesen na silikonih v kopalnici in oknih v kuhinji. Poizkušala sem za raznimi čistili, pa ni uspeha. Kako bi jo odstranila?"
Dobro vprašanje. Silikon je v bistvu zelo nevpojen material. Kako je sploh mogoče, da se plesen razraste na njem? Poglejmo v nadaljevanju.
Zakaj na silikonu nastane plesen?
Glavna lastnost silikona je, da je izredno elastičen in odbojen na tekočine. Iz tega bi lahko rekli, da plesen na njem težko nastane. Vendar ni tako.
Sam po sebi silikon še vedno predstavlja hranilne snovi za plesen. Voda res da zdrsi z njega, na stikih s poličkami ipd., se pa vseeno točkovno zadržuje v obliki kapljic.
Plesen svoje micelije (lahko rečete tudi korenine za lažjo predstavo) vraste v samo strukturo materiala. Na spodnji sliki so lepo vidne bele lasaste nitke, ki se razpredajo v strukturo gojišča. Tako se dogaja tudi na silikonu.
Kako to preprečiti?
Po vsakem tuširanju ali vidnem kondenzu na okenskih steklih, bi morali le tega obrisati s suho krpo. Tanek sloj vlage se bo hitro osušil in odpravil pogoje za nastanek plesni.
Kako plesen na silikonu odstraniti?
Zaenkrat še nisem našel zadovoljivega sredstva. To bi moralo biti takšno, da bi penetriralo globoko v silikon, kjer bi uničilo micelije plesni. Zgolj površinsko odstranjevanje pa ni najbolj zadovoljivo.
Spodaj primer, kjer je silikon delno premazan s Clox-om. Na desni sliki je vidna nekoliko posvetljena površina, še vedno pa rezultat ni zadovoljiv.

Rešitev?
Odstranitev silikona in na novo silikoniranje. Po zamenjavi pa skrbite, da obrišete vlago na mestih, kjer se zadržuje po tuširanju ipd.
Želite še več informacij o sanaciji plesni? Pojdite nazaj na seznam vprašanj s klikom tukaj: PLESEN ali pa pojdite nazaj na domačo stran: Slikopleskarstvo Kalinero.
Sedaj ste vi na vrsti
Imate kakšno dodatno idejo, mnenje, izkušnjo? S čim ste že poizkusili pa je ali ni delovalo? Komentirajte spodaj ali pa delite članek s kom, ki mu bo prav prišel.

